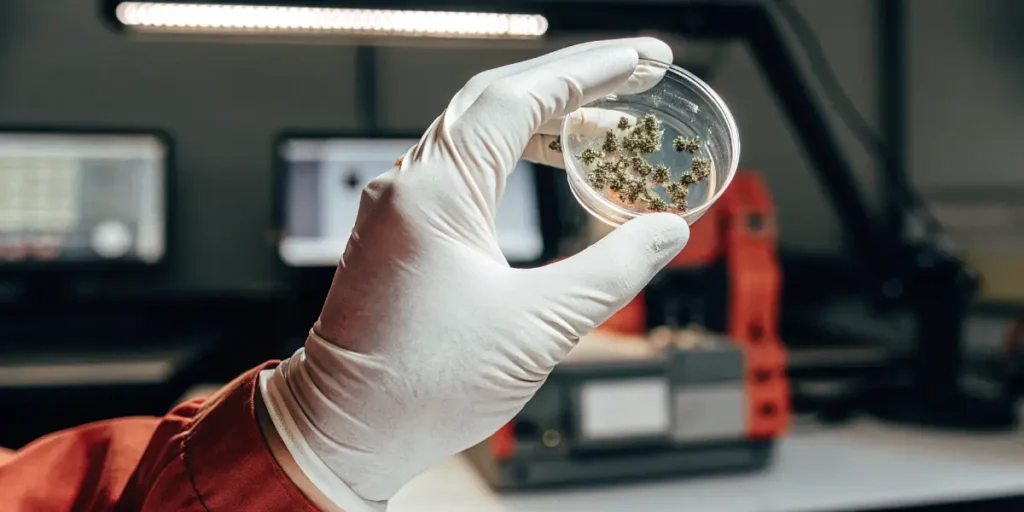
Cannabis genetic samples examined in a petri dish during advanced laboratory testing.

Discover the Best Certified Cannabis Seeds with Proven DNA Testing
Choosing certified cannabis seeds with DNA testing is crucial for both new buyers and seasoned growers. DNA testing ensures genetic authenticity, so you know exactly what you’re planting. This process verifies that the seeds you buy are genuinely what they claim to be, giving you peace of mind and a reliable growing experience.
When seeds are DNA tested, it means they’ve undergone rigorous analysis to confirm their genetic makeup. This way, you can avoid the disappointment of growing something unexpected. With this level of certainty, you can focus on nurturing your plants rather than worrying about their origins.
Recommended Strains
Bruce Banner #3
|
|
THC | 20% - 29% (High) |
|
|
Type | Feminized |
|
|
Yield | Medium |
|
|
Phenotype | 50% Indica / 50% Sativa |
Girl Scout Cookies
|
|
THC | 18% - 25% (High) |
|
|
Type | Feminized |
|
|
Yield | High |
|
|
Phenotype | 60% Indica / 40% Sativa |
Certified cannabis seeds with DNA testing from reputable companies like Blimburn Seeds ensure a high-quality crop. They offer a range of strains that have been verified for genetic authenticity, helping you achieve the best possible results in your garden.
The Importance of DNA Testing in Cannabis Seeds
DNA testing in cannabis seeds is not just a trend; it’s a necessity. As the market grows, so does the risk of mislabeled products. DNA testing acts as a safeguard against this, confirming that the seeds’ genetic profiles match their descriptions. This authenticity is crucial for growers who rely on specific strains for their characteristics.
Without DNA certification, you might end up with a strain that’s entirely different from what you intended. This can affect everything from growth patterns to THC levels. By choosing DNA-tested cannabis seeds, you ensure consistency and reliability, which is essential for both personal and commercial growers.
Certified cannabis seeds with genetic authenticity verification not only protect you from the pitfalls of mislabeled products but also provide a level of confidence that is invaluable in cultivation. Ensuring genetic precision helps in maintaining consistency in plant characteristics, which is crucial for breeders and medical growers who seek specific therapeutic properties in cannabis strains.
Moreover, certified cannabis seeds with DNA testing can play a critical role in research and development within the cannabis industry. Accurate genetic information allows scientists and breeders to study and enhance desirable traits, such as increased disease resistance or improved cannabinoid profiles, leading to the development of premium cannabis seed strains with DNA testing.
Promos & Deals
Benefits of Certified Cannabis Seeds
Certified cannabis seeds with genetic authenticity verification provide numerous advantages. First and foremost, they offer peace of mind. Knowing that your seeds have been tested and verified means you can trust in their quality and performance. This is especially important for growers who depend on specific traits for their crops.
Another benefit is the potential for higher yields. DNA-tested seeds are likely to produce more robust plants because they are true to their genetic potential. This means healthier growth and potentially more significant harvests, which is a win for any grower.
Besides to peace of mind and higher yields, certified cannabis seeds with DNA testing ensure that growers can optimize their cultivation practices effectively. With reliable cannabis seed genetics with certification, growers can tailor their growing environments to suit the exact needs of their chosen strains, maximizing the overall health and productivity of their crops.
Furthermore, DNA-tested cannabis seeds for growers reduce the risk of crop failure, leading to better financial outcomes and sustainability. Knowing precisely what you are growing allows for better planning and resource allocation, which is crucial for commercial growers seeking to maintain high-quality standards and consumer satisfaction.
Choosing the Right Strain from Blimburn Seeds
One excellent choice is the Bruce Banner 3 strain from Blimburn Seeds. Known for its potency and high THC levels, Bruce Banner is a favorite among growers looking for a strong, reliable plant. Its DNA certification ensures you get the exact characteristics you’re aiming for.
Another top pick is the Girl Scout Cookies strain. This strain is renowned for its unique flavor profile and balanced effects. With DNA-tested cannabis seeds, you can be sure of growing a plant that delivers the expected sweet, earthy aroma and potent high.
For those interested in a classic, the GG4 strain offers a strong, sticky experience. This strain’s reliable cannabis seed genetics with certification means you can grow with confidence, knowing your effort will yield the popular, resin-heavy buds that GG4 is famous for.
When selecting strains from Blimburn Seeds, it’s important to consider your specific growing goals and climate conditions. Each strain has unique characteristics that may thrive better in particular environments or under specific light conditions. By knowing these requirements, you can choose certified cannabis seeds with DNA testing that align with your cultivation plans.
As a trusted provider, Blimburn Seeds not only offers high-quality cannabis seeds with DNA certification but also provides detailed information and support for growers. This ensures that you not only start with the best seeds but also have the resources to nurture them into thriving plants, enhancing your overall growing experience.
How DNA Testing Works
DNA testing in cannabis seeds involves analyzing the genetic material to verify its identity. This process can be complex, but it essentially compares the DNA of your seeds with a known database to confirm their strain. This ensures that each seed truly matches the advertised strain description.
Labs use advanced techniques to extract and analyze DNA from the seeds. This analysis can reveal not only the strain but also potential traits like disease resistance or growth patterns. It’s a powerful tool for growers who want to maximize their crop’s potential.
The process of DNA testing begins with the careful extraction of genetic material from the seeds. Once extracted, this material is subjected to a series of tests that compare it to a comprehensive database of known cannabis strains. This comparison helps in confirming the strain’s identity, ensuring that growers receive exactly what they expect.
Beyond just identification, DNA testing can also offer insights into the plant’s genetic predispositions, such as flowering time, cannabinoid content, and resistance to pests. This information is invaluable for growers who aim to cultivate premium cannabis seed strains with DNA testing, as it allows for better planning and optimization of growing conditions.
FAQs about certified cannabis seeds with DNA testing
What are certified cannabis seeds with DNA testing?
Certified cannabis seeds with DNA testing are seeds that have undergone scientific analysis to confirm their genetic makeup. This process ensures that the seeds are true to the strain they are advertised as, providing growers with assurance about their purchase.
This certification process helps prevent the issues of mislabeled seeds, which can lead to unexpected and unwanted plant characteristics. For growers, this means more reliable crops and better alignment with their growing goals.
By investing in certified cannabis seeds with DNA testing, growers can avoid the common pitfalls of cultivating mislabeled or substandard seeds. This leads to a more streamlined and effective growing process, where the focus can be on nurturing plants rather than troubleshooting unexpected outcomes.
The reliability provided by DNA testing also supports growers in achieving their desired end product, whether that be for recreational use, medical applications, or commercial sale. The precision and predictability of certified cannabis seeds with genetic authenticity verification make them a wise choice for dedicated cultivators.
Why is DNA testing important for cannabis seeds?
DNA testing is crucial because it provides a layer of verification for the seeds you purchase. Without it, you risk growing plants that don’t meet your expectations, whether in terms of potency, yield, or growth behavior. DNA testing helps ensure consistency and quality.
For those who grow for specific traits, such as medicinal properties or THC content, DNA testing is even more important. It guarantees that the seeds will produce plants with the desired characteristics, making it a worthwhile investment.
As the cannabis industry continues to expand, the importance of DNA testing grows alongside it. With the increasing demand for specialized strains, having high-quality cannabis seeds with DNA certification becomes critical for meeting market needs and maintaining a competitive edge.
Furthermore, DNA testing supports breeders in developing new strains with targeted characteristics, contributing to innovation within the industry. By utilizing certified cannabis seeds with DNA testing, growers and breeders can confidently explore new possibilities and improve existing strains.
How does DNA testing verify cannabis seed genetics?
DNA testing verifies cannabis seed genetics by comparing the genetic material of the seeds to a database of known strains. This comparison confirms that the seeds are indeed the strain they claim to be, eliminating the guesswork for growers.
For growers, this means that the time, effort, and resources invested in cultivation are more likely to yield the expected results. It also reduces the risk of growing a less desirable strain that might not meet your needs.
Through DNA testing, both novice and experienced growers gain access to a wealth of genetic information about their seeds. This transparency fosters confidence and allows for more informed decisions regarding cultivation techniques and expectations for the final product.
Additionally, verified genetics from DNA testing help ensure that the plants exhibit consistent traits across different growing cycles. This level of predictability is particularly advantageous for commercial growers who need to meet consumer expectations consistently.
Can DNA-tested seeds improve my growing experience?
Yes, DNA-tested seeds can significantly enhance your growing experience. With proven genetics, you have a better knowing of what to expect from your plants, which allows for more precise cultivation strategies. This can lead to healthier plants and better yields.
Furthermore, knowing the exact strain helps you tailor your growing environment to maximize the plant’s potential, whether it’s optimizing light, nutrients, or water. This level of control can lead to a more successful and rewarding cultivation experience.
Besides to improving yield and plant health, DNA-tested cannabis seeds for growers also contribute to sustainability by reducing the likelihood of crop failure. With accurate genetic information, growers can minimize waste and utilize resources more efficiently, aligning with eco-friendly practices.
Ultimately, the use of certified cannabis seeds with DNA testing enhances not just the physical aspects of growing but also the overall experience. The confidence and satisfaction derived from growing a successful crop from reliable cannabis seed genetics with certification cannot be understated, making the investment worthwhile for any serious cultivator.
Where can I buy high-quality cannabis seeds with DNA certification?
Blimburn Seeds is an excellent source for high-quality cannabis seeds with DNA certification. They offer a variety of strains that have been tested for genetic authenticity, ensuring you receive the exact strain you want to grow.
By choosing a reputable provider like Blimburn Seeds, you can trust that your seeds come with reliable cannabis seed genetics with certification. This provides a solid foundation for a successful growing endeavor, whether you’re a hobbyist or a professional.
When purchasing from Blimburn Seeds, you’re not just obtaining seeds; you’re investing in a promise of quality and authenticity. Their commitment to providing certified cannabis seeds with DNA testing ensures that every seed meets stringent standards and offers the best potential for success in your garden.
Besides to their wide selection of premium cannabis seed strains with DNA testing, Blimburn Seeds also offers customer support and resources to help you make the most of your growing experience. This holistic approach to seed sales makes them a preferred choice for discerning growers who prioritize quality and reliability.


